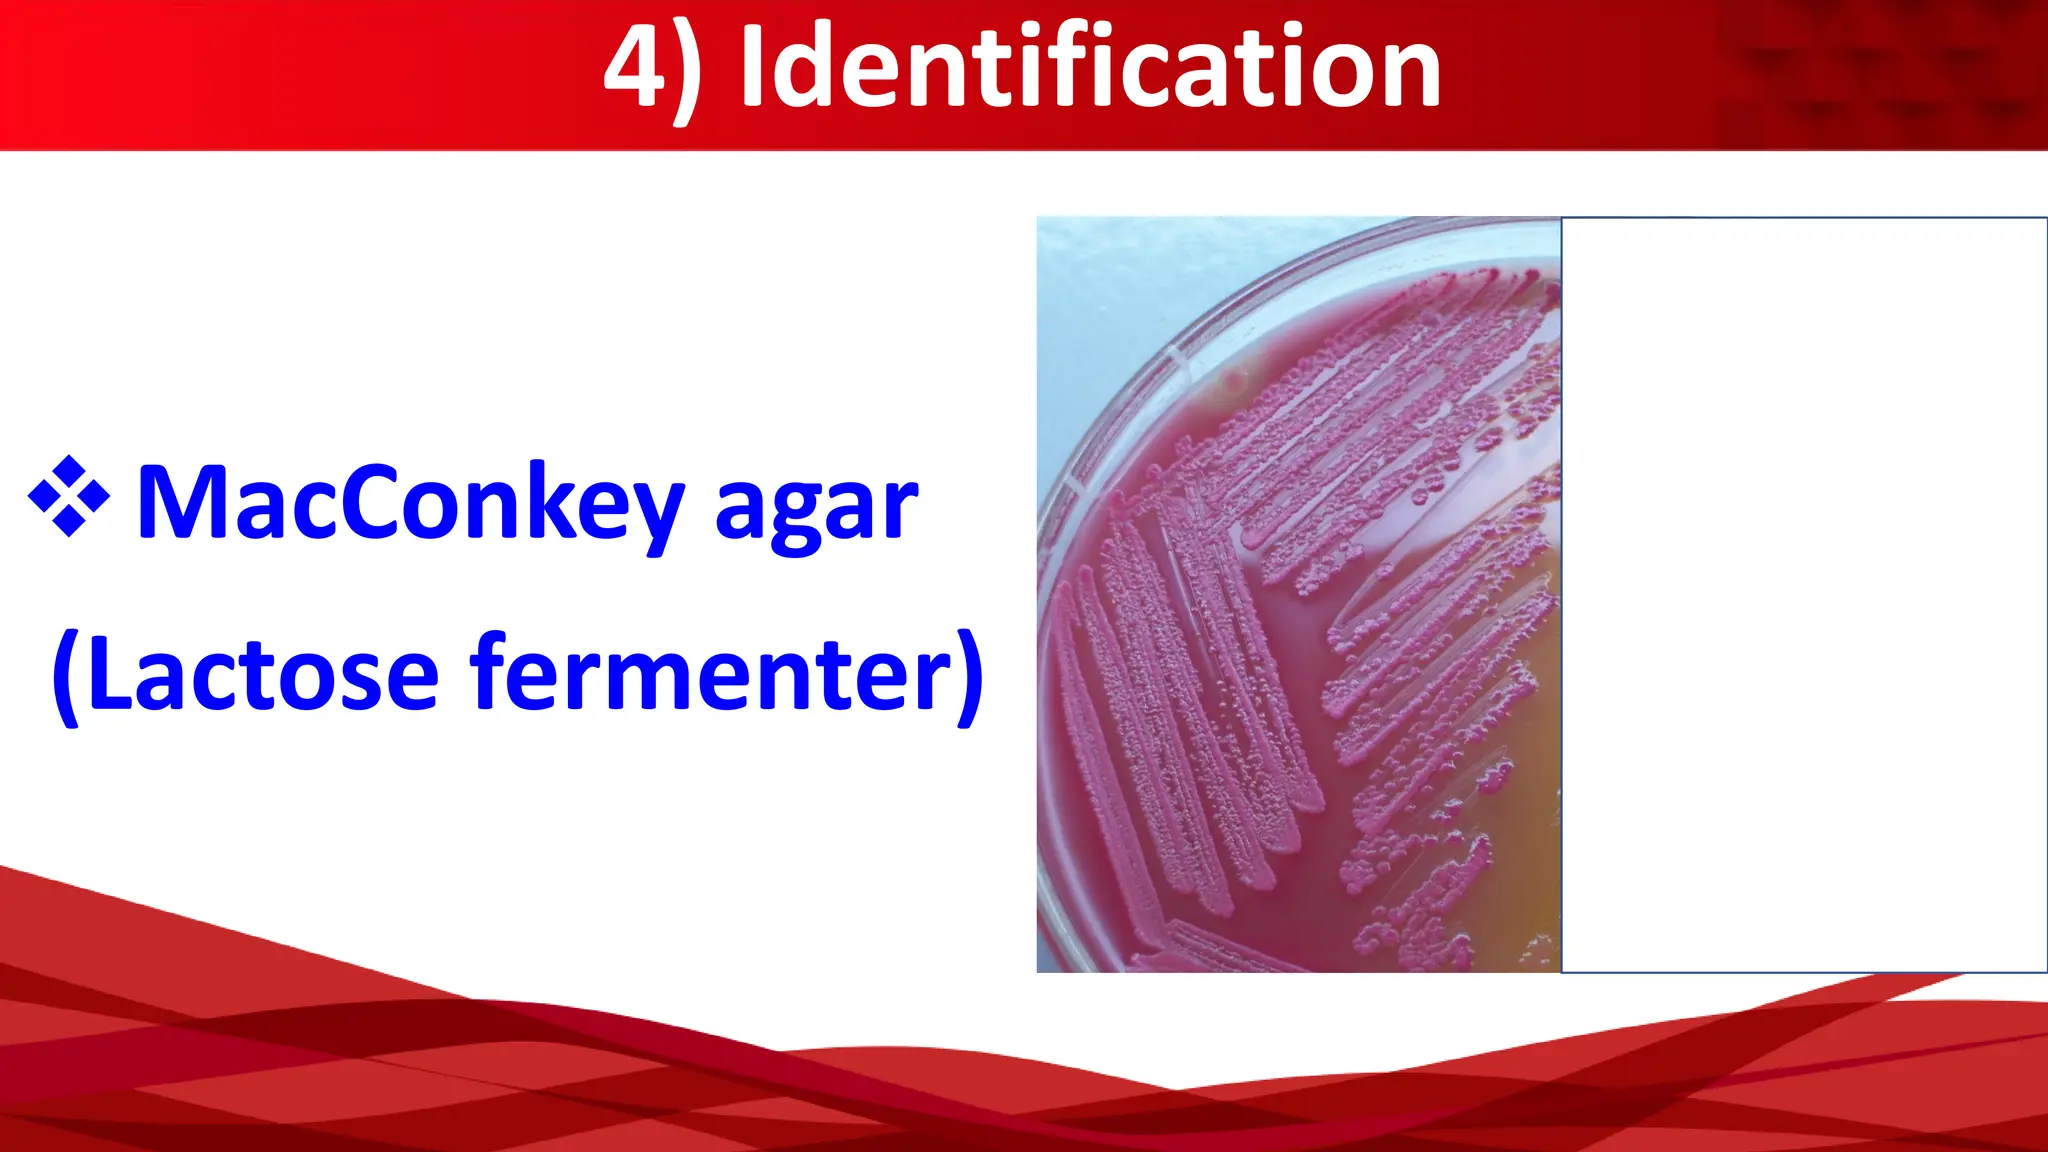
4) Identification
(Lactose fermenter)
❖MacConkey agar

The document provides an overview of Enterobacteriaceae, focusing particularly on Escherichia coli (E. coli), which is a significant opportunistic pathogen. It details the general characteristics, classification, virulence factors, and associated diseases caused by various strains of E. coli, including urinary tract infections, sepsis, and gastrointestinal illnesses. Additionally, it outlines laboratory diagnosis methods and treatment options relevant to E. coli infections.